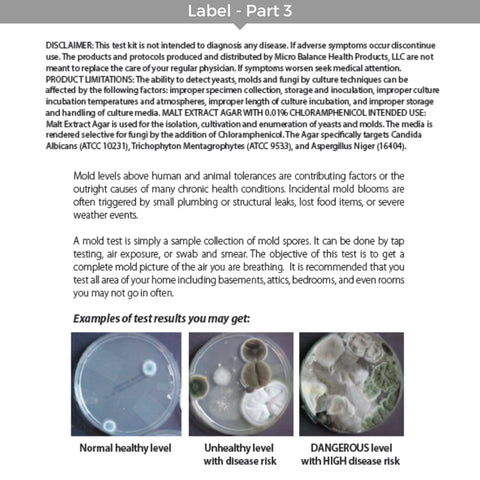
Micro Balance Health Products EC3 Mold Screening Test Kit, 6 Pack Mold Screening Test Kit Micro Balance Health Products

Micro Balance Health Products EC3 Mold Screening Test Kit, 6 Pack
EC3 Mold Screening Test Kit is an effective mold detection kit that includes everything you need to test for elevated levels of mold in your indoor air or on belongings. Each kit includes 6 mold test plates, as well as detailed instructions on how to perform a test for the presence of mold in your indoor air or on specific items and/or surfaces. It takes just a few minutes to test, and you can use the package insert to read your results in just 5 days.
Note: This is NOT a diagnostic test and does NOT provide information as to the species or types of mold present. This test kit does not include laboratory analysis.
Want Your Test Plates Analyzed?
If you would like to send your plates in for analysis, we have partnered with IMS Laboratory (Official Laboratory for the National Association of Mold Professionals), a fully accredited, full-service microbiology lab, to offer additional testing services. Please see the link below for more information on lab testing and to download and print the forms and instructions for those services. We advise to ONLY send in the test plates that grow out mold as lab analysis is an additional fee and is charged per plate.
Product Details
Directions For Use:
(Note: Detailed instructions and a results key are included with each kit.) For Air Testing: Enter room or area that you wish to test. Remove test plate from clear plastic sleeve. Take lid off test plate and place open plate on a flat surface away from walls and windows. Place lid open side down next to the test plate. Go about your activities as normal. After 1 hour, place lid back on top of test plate. Seal plate closed with tape. Wrap sealed plate in aluminum foil. Label wrapped plate with name of room or space tested and date. Place wrapped and labelled plate in a drawer or cabinet. When 5 days have elapsed since the date of testing, remove the aluminum foil to reveal results. DO NOT unseal or open test plate. Use the KEY included with the test kit to determine your results. If further diagnostics testing is needed, use one of the Environmental Mycotoxin Tests. Dispose of used test plates in outside trash receptacle. To Test Specific Items: Remove test plate from clear sleeve. Remove lid from test plate and set aside. Gently tap the item you wish to test with the plate 1-2 times. Make sure that the agar material is exposed to the item being tested when tapping. The puffs of air created from the tapping motion will cause any mold spores embedded in the item to attach to the agar material. Place lid back on test plate. Seal plate closed with tape. Wrap sealed plate in aluminum foil. Label wrapped plate with name of object tested and date. Place wrapped and labelled plate in a drawer or cabinet. When 5 days have elapsed since the date of testing, remove the aluminum foil to reveal results. DO NOT unseal or open test plate. Use the KEY included with the test kit to determine your results. Note: Each plate has an expiration date. Use before expiration date. As plates age, water will begin to condense onto the top of plate and may pool inside the plate. When you are ready to perform test, drain excess water from the plate first. Since the plates do expire, we do not accept returns for refunds.

